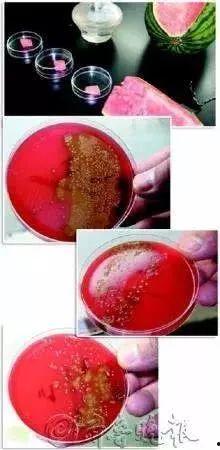

表面实际吃瓜,揭秘表面吃瓜背后的真实故事
亲爱的读者们,今天我要和你聊聊一个超级热门的话题——吃瓜!没错,就是那个让你在茶余饭后津津乐道的“吃瓜群众”。咱们一起来揭开这个话题的神秘面纱,看看它背后的真相吧!
一、吃瓜的起源

说起吃瓜,这可是我国民间流传已久的传统活动。据说,最早起源于古代宫廷,那时候的宫女们闲暇之余,就会聚在一起,边吃瓜边八卦,以此来消磨时光。后来,这个习俗逐渐流传到民间,成为了人们茶余饭后的消遣方式。
二、吃瓜的乐趣
那么,吃瓜究竟有什么乐趣呢?首先,吃瓜可以让你紧跟时事,了解娱乐圈、政界、体育界等各个领域的最新动态。其次,吃瓜还能让你感受到一种“参与感”,仿佛自己就是那个事件的见证者。最重要的是,吃瓜可以让你在紧张的工作、学习之余,放松心情,享受生活。
三、吃瓜的误区

吃瓜也有它的误区。有些人过度沉迷于吃瓜,以至于忽略了现实生活中的重要事情。比如,有些人为了追星,不惜花费大量时间和金钱,甚至影响到正常的生活和工作。此外,过度吃瓜还可能导致信息过载,让人陷入焦虑和恐慌。
四、如何正确吃瓜
那么,如何才能正确地吃瓜呢?以下是一些建议:
1. 保持理性:在吃瓜的过程中,要保持理性思考,不要盲目跟风,更不要被情绪所左右。
2. 关注事实:吃瓜时要关注事实,不要被谣言和虚假信息所误导。
3. 适度原则:合理安排时间,不要让吃瓜占据你生活的全部。
4. 学会分辨:在众多信息中,要学会分辨哪些是真实的,哪些是虚假的。
五、吃瓜的启示
吃瓜虽然是一种娱乐方式,但它也给我们带来了一些启示。首先,我们要学会关注社会热点,关心国家大事。其次,我们要保持一颗平常心,对待生活中的各种事件。我们要学会分辨是非,不被虚假信息所蒙蔽。
吃瓜是一种生活态度,也是一种娱乐方式。只要我们正确地吃瓜,就能在轻松愉快的氛围中,度过美好的时光。亲爱的读者们,让我们一起加入吃瓜大军,享受这个充满乐趣的世界吧!



